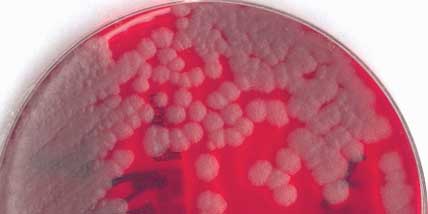

|
Seule la suite des examens bactériologiques du malade pour lequel l'examen direct a été montré sera rapportée.
|
- Caractères culturaux : Voici la coproculture après 24 h d'incubation à 37°C en atmospère ambiante ou non sur divers milieux dont ceux habituellement ensemencés:
Milieu de Drigalski (à gauche), milieu de Chapman (à droite) et milieu SS (non montré)
Milieu pour Campylobacter et en atmosphère microaérophile

- Compte tenu des commémoratifs de cette coproculture comme l'examen direct, le biologiste de garde a ensemencé des géloses au sang frais à 37°C en aérobiose et en anaérobiose dont le résultat est montré ci-dessous:
Milieu au sang frais en anaérobiose

Milieu au sang frais en aérobiose
- Morphologie: Voici à nouveau, l'aspect après coloration de Gram (G X 1000) :

- Caractères d'identification rapide: Examiner les aspects observés après 30 secondes de contact


- Autres caractères d'identification :
Les autres caractères d'identification biochimique sont examinés à l'aide d'une galerie d'identification biochimique API 20E après 24 h d'incubation à 37°C en aérobiose.


Veuillez lire l'antibiogramme avant la validation définitive
|
|
|
|
|